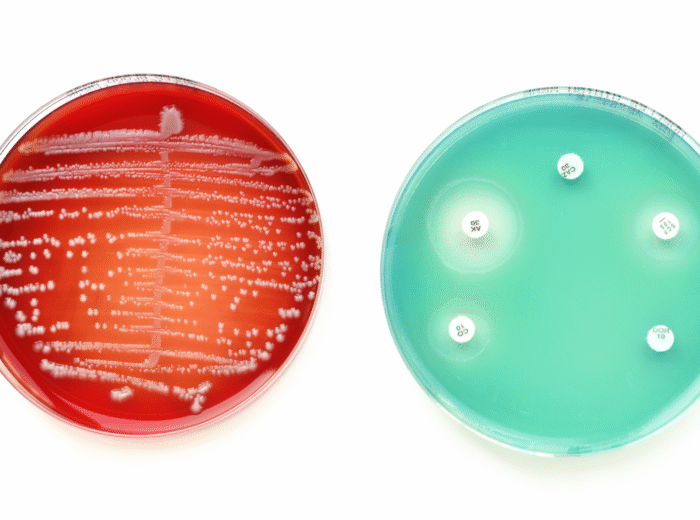

Discover Your Fertility Options
Private Fertility Concierge
Experience personalised fertility guidance with a dedicated concierge, tailored to your needs.
Learn More
Couple's Fertility Assessment
Comprehensive testing and consultation for couples, helping you understand your fertility journey.
Learn More
Folate Receptor Autoantibody
Check for folate receptor autoantibodies, a crucial step for reproductive health insights.
Learn More
Early Pregnancy Symptoms: The Very First Signs Before a Missed Period
Wondering if you might be pregnant? Early pregnancy symptoms can begin before a missed period. However, every woman

Weight Loss Safety Panel
Essential Blood Tests Before & During Medical Weight Loss Weight loss medications are not vitamins.They change how your

Why Am I Tired?
The Advanced Fatigue Blood Test Panel in Central London Feeling tired all the time is not normal.Yet many

Fertility Readiness Check
Are You Biologically Ready to Conceive? Many couples assume fertility is automatic.For some, it is.For many, it is

What Is the AMH Test For NHS Access, Normal Levels, PCOS & Private Testing Explained
Author: Dr Lauren, Clinical Lead – Marylebone Diagnostic Centre The AMH test is one of the most misunderstood

Egg Quality and Fertility: What Blood Tests Can (and Can’t) Tell Us
Dr Lauren Holland Egg quality plays a central role in fertility, IVF success, and early embryo development. But

AMH Explained: The Most Useful Fertility Blood Test in 2025
Author: Dr. Lauren Holland AMH is one of the most requested fertility blood tests today. But what does

How a London Diagnostic Centre Built an AI-Driven Semen Analysis Platform
From Manual Microscopy to Machine-Assisted Insight — and Why This Shift Matters for Male Fertility Care in 2026

The MDC Diagnostic Stack Blood, Semen, Urine & IV Therapy – One Clinical Intelligence Model
Why Modern Healthcare Outcomes Depend on Integrated Diagnostics, Not Isolated Tests Introduction: The Problem with Single-Test Medicine Most

Why Diagnostics Is the Next Frontier of Longevity Medicine
How early biological signals, trend-based testing, and data-led decisions are redefining ageing care Longevity Is Not a Supplement

FRAT Test for Children – Clinical Information & FAQs for Families
Reviewed by Dr Lauren & Clinical Team Marylebone Diagnostic Centre (MDC) Why Families Search for the FRAT Test

Using AI Vision to Improve Reproductive Health Outcomes
How MDC applies computer vision to reduce variability, improve consistency, and deliver clearer fertility decisions When outcomes depend

From Clinic to Platform: MDC’s Data-Driven Fertility Diagnostics
Why modern fertility care demands integrated diagnostics – not isolated tests Introduction: fertility diagnostics reached a turning point.

Understanding Your Semen Analysis Results – What the Numbers Really Mean in London
Reviewed by Dr Lauren Holland • Marylebone Diagnostic CentreResults within 24 - 42 hours • Central London •

WHO Releases New 2025 Infertility Guideline – What It Means for Patients in London
The World Health Organization (WHO) has published its first global guideline on infertility (2025), and the findings are

High Cholesterol Warning Signs: What to Look for on Your Face & Body
By Dr Lauren Holland, Marylebone Diagnostic Centre High cholesterol is often called a silent condition because most people

Private Blood Tests in London – Why Choose Marylebone Diagnostic Centre
By Tharb Faisl Getting timely answers about your health is vital. Yet, in London, many patients find themselves

Mounjaro Monitoring in London – The Essential Blood Tests Every Patient Should Know
Marylebone Diagnostic Centre - 73 Baker Street, W1U 6RD Mounjaro is changing the weight loss world. But like

A Comprehensive Guide to Private Blood Tests in Central London
Same‑day private blood tests in central London with clear reports, optional clinician reviews, and rapid results (many within

فحوصات خصوبة الرجال في لندن – مارليبون للتشخيص
تحليل السائل المنوي وفحوصات الخصوبة للرجال في لندن | Marylebone Diagnostic Centre تحليل خصوبة الرجال في لندن –

Mineral Hair Test in London – Uncover Hidden Deficiencies
By Tharb Faisl Have you been feeling unwell without clear answers from standard blood tests? Mineral hair testing

Blood Analysis Near Me: What It Reveals About Your Health
By Tharb Faisl Your blood holds the key to understanding your overall health. Whether you're feeling unwell, managing

Private Blood Tests in London – Fast, Accurate & Confidential
By Tharb Faisl Looking for a same-day blood test near you? At Marylebone Diagnostic Centre, we provide private

Why Book Your Glutathione Test or IV Therapy in London Today?
By Tharb Faisl Glutathione, often dubbed the "master antioxidant," plays a pivotal role in maintaining our health by

How Much Vitamin D Do I Really Need? Vitamin D Test London!
By Tharb Vitamin D isn’t just about sunshine - it’s a key hormone that affects your immune system,

On GLP-1 Weight Loss Injections?
Check Your Hormones, Liver, Kidneys, and Fertility MarkersThinking of using GLP-1 injections?Or already on Mounjaro, Ozempic, or Wegovy?Weight-loss

Cotinine Test in London
Same-Day Urine Nicotine Testing ExplainedNeed proof of smoking or nicotine use?A cotinine test is the most accurate way

Semen Analysis in London – Private Sperm Test with Fast Results
Looking for a Semen Analysis in London?If you are searching for:“Semen analysis near me”“Private sperm test London”“Sperm count

Recurrent Miscarriage: The Male Factor Explained
Recurrent Miscarriage Is Not Always a Female IssueWhen miscarriage happens repeatedly, attention often turns to the woman.Hormones.Uterine structure.Chromosomal

Sperm DNA Fragmentation Test in London: What It Means for Male Fertility
What Is the DNA Fragmentation Test?A sperm DNA fragmentation test measures the integrity of genetic material inside sperm

AMH & Ovarian Reserve Testing in London: What Your Egg Reserve Really Means
Thinking About Your Fertility? Start With Ovarian ReserveMore women in London are asking the same question:“What is my

Can Pre-Diabetes Be Reversed? Early Signs, Blood Tests & Prevention in London
Pre-diabetes is common in the UK. However, many people do not know they have it. Blood sugar levels

Type 2 Diabetes Management in 2026: What the Latest NICE Guidance Means for You in London
IntroductionType 2 diabetes is one of the most common long-term health conditions in the UK.However, management has changed

Heavy Periods: When Is It Too Much?
Heavy periods are common. However, extremely heavy bleeding is not normal. Many women assume they must “just cope.”

Painful Periods: When Is Period Pain Not Normal?
Mild discomfort during a period can be normal. However, severe pain is not normal.If your period causes intense

Why Is My PMS So Bad?
Severe PMS Symptoms, PMS Rage, PMDD & What Actually HelpsAuthor: Dr Lauren HollandAre you searching:Why are my PMS

Female Health MOT: What a Women’s Health Check Includes, Costs & Whether It’s Worth It
A Female Health MOT, also known as a Well Woman Check, is a structured health assessment designed to

Severe PMS Symptoms: Why They Happen, How Bad They Can Get & When to Get Help
Severe PMS symptoms can feel overwhelming.Many women describe rage, anxiety, exhaustion, or feeling unlike themselves.If PMS is affecting

PMS in the UK: Symptoms, Causes, When It Starts & How to Get Help
Premenstrual Syndrome (PMS) affects millions of women in the UK.Yet many still feel confused, dismissed, or told their

New European IVF Laboratory Standards 2026: What London Patients Should Check Before Starting IVF
New European IVF Laboratory Standards 2026: What Patients Should Know Before Treatment Fertility treatment continues to evolve across

Low Energy, Brain Fog or Gym Plateaus?
Blood Tests Every Man Should Consider in London Author: Dr Lauren Holland, Clinical Lead – Marylebone Diagnostic Centre

How Long Should Couples Try Before Fertility Testing?
Doctors’ Real Answers, Explained Clearly Author: Dr Lauren Holland, Clinical Lead – Marylebone Diagnostic Centre Many couples ask

Advanced Female Health Screening in London
What It Tests, Why It Matters, and Who It’s For Author: Dr Lauren Holland, Clinical Lead – Marylebone

Advanced Male Health Screening in London
What It Tests, Why It Matters, and Who It’s For Author: Dr Lauren Holland, Clinical Lead – Marylebone

Couples Fertility Assessment in London
A Complete Guide to Fertility Blood Testing for Both Partners Author: Dr Lauren Holland, Clinical Lead – Marylebone

Always Tired, Bloated, Anxious or Gaining Weight?
Blood Tests Every Woman Should Consider in London Author: Dr Lauren Holland, Clinical Lead – Marylebone Diagnostic Centre

Breast Cancer, Hormones, and Missed Warning Signs: Why Blood Tests Still Matter
Recent UK media coverage has highlighted tragic cases where breast cancer symptoms were initially dismissed as hormonal changes.While

Bowel Cancer Screening Is Improving — But Blood Tests Still Matter
The NHS has announced improvements to bowel cancer screening accuracy by refining FIT testing thresholds.This is a positive

Vitamin D and Omega-3: Why “More” Is Not Always Better
Recent media reports have warned against unmonitored vitamin D use, while omega-3 supplements continue to be widely promoted.The

Nipah Virus: Why Immune Health Matters More Than Headlines
When news stories mention rare viruses, concern spreads quickly. However, most serious outcomes depend on immune resilience, not

Male Hormone MOT
Testosterone, Energy & Performance Testing in Central London Low energy is not just “getting older”.Loss of drive is

High AMH and PCOS Explained: What Elevated AMH Really Means
High AMH Explained Author: Dr Lauren, Clinical Lead – Marylebone Diagnostic Centre A high AMH result is often

AMH vs FSH: Which Fertility Hormone Test Matters More?
Author: Dr Lauren, Clinical Lead – Marylebone Diagnostic Centre Patients are often told conflicting things about fertility hormones.

AMH Test in London: Price, NHS Access, At-Home Kits, Results & When to Test
Author: Dr Lauren, Clinical Lead – Marylebone Diagnostic Centre Understanding your fertility should never feel rushed or confusing.

Low AMH Explained: What It Really Means for Fertility
Author: Dr Lauren, Clinical Lead – Marylebone Diagnostic Centre Being told you have a low AMH can feel

Feeling “Mostly Fine” but Still Worried? Why an Adult Blood Test in London Makes Sense
Reviewed by Dr Lauren Holland • Marylebone Diagnostic CentrePrivate testing in Central London. Results in 24 - 42

Always Tired? A Private Fatigue Blood Test in London Can Find the Cause
Who This Test Is For (Read This First) This service is for you if you feel constantly tired,

Adult Blood Tests in Central London – What Can Be Checked in One Visit?
Marylebone • Baker Street • Central London If you are searching for an adult blood test in Central

Private Blood Tests in Central London – Same-Day Appointments
Fast, private blood testing in Marylebone with results in 24 - 42 hours.No GP referral. No waiting lists.

How to Check Your Liver Health After Binge Drinking?
Reviewed by Dr Lauren Holland • Marylebone Diagnostic CentreResults within 24 - 42 hours. Westminster residents receive 20%

Burning After Sex but No Discharge?
Reviewed by Dr Lauren Holland • Marylebone Diagnostic CentreResults within 24 - 42 hours. Westminster residents receive 20%

Advanced Thyroid Blood Tests: Beyond TSH in Private Clinics
Reviewed by Dr Lauren Holland • Marylebone Diagnostic CentreResults within 24–42 hours. Westminster residents receive 20% off. Thyroid

Adult Blood Tests in Central London: What We Can Check in One Visit
Reviewed by Dr Lauren Holland • Marylebone Diagnostic CentreResults within 24 - 42 hours. Westminster residents receive 20%

Bleeding or Pain After a Smear Test – What’s Normal and What’s Not?
Reviewed by Dr Lauren Holland • Marylebone Diagnostic CentreResults within 24 - 42 hours. Westminster residents receive 20%

Male Fertility Testing in London – From Semen Analysis to DNA Fragmentation and Hormone Testing
Male fertility issues are common, yet often under-tested.Around 50% of infertility cases involve a male factor. At Marylebone

Sperm / Semen Analysis
A semen analysis is the main test used to assess male fertility. It checks sperm count, motility, morphology,

How Often Should You Have a Smear Test in the UK?
Reviewed by Dr Lauren Holland • Marylebone Diagnostic CentreResults within 24–42 hours. Westminster residents receive 20% off. Note:

2-Week Pregnancy hCG Levels – What Blood Tests Can Tell You
Reviewed by Dr Lauren Holland • Marylebone Diagnostic CentreResults within 24–42 hours. Westminster residents receive 20% off. Many

Why Do My Armpits Still Smell After a Shower? Medical Reasons Explained
Many people wonder why they smell even after washing. It can be embarrassing, frustrating, and confusing - especially

10 Causes of Body Odour – When Is It a Medical Problem?
Reviewed by Dr Lauren Holland • Marylebone Diagnostic CentreResults within 24 - 42 hours. Westminster residents receive 20%

Smear Tests in the UK – How Often Should You Have One & What Women Need to Know in 2025
Smear testing (cervical screening) is one of the most effective ways to prevent cervical cancer. It detects abnormal

Cervical Screening in London – How Often Should You Have a Smear Test?
Reviewed by Dr Lauren Holland • Marylebone Diagnostic CentreResults within 24 - 42 hours. Westminster residents receive 20%

Sexual Health & HIV Testing in London – Fast, Private 4th Generation Tests
Reviewed by Dr Lauren Holland • Marylebone Diagnostic CentreResults within 24 - 42 hours. Westminster residents receive 20%

Coagulation Profile Test – Cost, Purpose & Fast Results in London
Reviewed by Dr Lauren Holland • Marylebone Diagnostic CentreResults within 24 - 42 hours. Westminster residents receive 20%

Pre-Marriage & Pre-Wedding Health Screening for Couples in London
What MDC offers, why choose us, and how to book your pre-wedding health check. Before you exchange vows,

Pre-Marriage Check up in London: What Every Couple Should Know – Book Now
Pre-marriage Blood Test – £349 Why pre-marital screening matters in the UK and what tests you might consider

Semen, Sperm and Male Fertility: What’s Normal, What Isn’t, and When to Test
Written by Marylebone Diagnostic Centre – London’s leading clinic for private semen analysis.Over 30 semen tests performed every

Daily Headaches in London?
Reviewed by Dr Lauren Holland • Marylebone Diagnostic CentreResults within 24 - 42 hours. Westminster residents receive 20%

Burning When You Urinate in London?
Reviewed by Dr Lauren Holland • Marylebone Diagnostic CentreResults within 24 - 42 hours. Westminster residents receive 20%

Lower Abdominal Pain in London?
Reviewed by Dr Lauren Holland • Marylebone Diagnostic CentreResults within 24 - 42 hours. Westminster residents receive 20%

Fatigue and Low Energy in London
Reviewed by Dr Lauren Holland • Marylebone Diagnostic CentreResults within 24 - 42 hours. Westminster residents receive 20%

STD Symptoms in Women
Marylebone Diagnostic CentreResults within 24–42 hours. Westminster residents receive 20% off. Sexually transmitted infections often show no early

How Soon After Sex Should You Test for STDs?
Marylebone Diagnostic CentreResults within 24 - 42 hours. Westminster residents receive 20% off. After unprotected sex or a

Pain During Sex – When to Test for Infection or Inflammation
Dr Lauren Holland • Marylebone Diagnostic CentreResults within 24 - 42 hours. Westminster residents receive 20% off. Pain

Pain Under the Left Rib – Stomach, Pancreas or Gas? What Tests Reveal
Dr Lauren Holland • Marylebone Diagnostic CentreResults within 24 - 42 hours. Westminster residents receive 20% off. Pain

Pain After Drinking Alcohol – When to Check Your Liver
Dr Lauren Holland • Marylebone Diagnostic CentreResults within 24 - 42 hours. Westminster residents receive 20% off. Pain

Joint Pain and Stiffness in London – Could It Be Deficiency or Inflammation?
Dr Lauren Holland • Marylebone Diagnostic CentreResults within 24 - 42 hours. Westminster residents receive 20% off. Joint

Lower Back Pain with Fatigue – When to Test Iron & Kidneys
Dr Lauren Holland • Marylebone Diagnostic CentreResults within 24 - 42 hours. Westminster residents receive 20% off. Lower

Shoulder Pain and Weakness – Could It Be Vitamin or Thyroid Related?
Reviewed by Dr Lauren Holland • Marylebone Diagnostic CentreResults within 24 - 42 hours. Westminster residents receive 20%

Rib Pain and Side Pain – When It’s More Than Muscular
Reviewed by Dr Lauren Holland • Marylebone Diagnostic CentreResults within 24 - 42 hours. Westminster residents receive 20%

Night Leg Cramps in London – What Blood Tests Reveal
Reviewed by Dr Lauren Holland • Marylebone Diagnostic CentreResults within 24 - 42 hours. Westminster residents receive 20%

Pelvic Pain in Women – Infection, Hormones or Deficiency? What Tests Reveal
Reviewed by Dr Lauren Holland • Marylebone Diagnostic CentreResults within 24 - 42 hours. Westminster residents receive 20%

Upper Abdominal Pain After Eating – When to Test Your Liver & Pancreas
Reviewed by Dr Lauren Holland • Marylebone Diagnostic CentreResults within 24 - 42 hours. Westminster residents receive 20%

Unexplained Weight Gain in London – Thyroid, Vitamins or Hormones? What Tests Reveal
Reviewed by Dr Lauren Holland • Marylebone Diagnostic CentreResults within 24 - 42 hours. Westminster residents receive 20%

Hair Loss in Women – What Blood Tests Reveal (London Guide)
Reviewed by Dr Lauren Holland • Marylebone Diagnostic CentreResults within 24 - 42 hours. Westminster residents receive 20%

Breathlessness in London – When You Need Early Heart Testing
Reviewed by Dr Lauren Holland • Marylebone Diagnostic CentreResults within 24 - 42 hours. Westminster residents receive 20%

Daily Headaches in London – Are Blood Tests Needed?
Reviewed by Dr Lauren Holland • Marylebone Diagnostic CentreResults within 24 - 42 hours. Westminster residents receive 20%

Burning When You Urinate in London – UTI or STI? What Tests You Need
Reviewed by Dr Lauren Holland • Marylebone Diagnostic CentreResults within 24 - 42 hours. Westminster residents receive 20%

Lower Abdominal Pain in London – When You Need Blood or Urine Tests
Reviewed by Dr Lauren Holland • Marylebone Diagnostic CentreResults within 24 - 42 hours. Westminster residents receive 20%

Stomach Pain After Eating – What Blood Tests Can Reveal (London Guide)
Reviewed by Dr Lauren Holland • Marylebone Diagnostic CentreResults within 24 - 42 hours. Westminster residents receive 20%

Chest Tightness in London – When You Need a Heart Test
Reviewed by Dr Lauren Holland • Marylebone Diagnostic CentreResults within 24 - 42 hours. Westminster residents receive 20%

Dizziness and Light-headedness in London – Causes & Blood Tests to Consider
Reviewed by Dr Lauren Holland • Marylebone Diagnostic CentreResults within 24 - 42 hours. Westminster residents receive 20%

Fatigue and Low Energy in London – What Blood Tests Reveal
Reviewed by Dr Lauren Holland • Marylebone Diagnostic CentreResults within 24 - 42 hours. Westminster residents receive 20%

STD Symptoms in Women – Early Signs Most People Miss
Marylebone Diagnostic CentreResults within 24–42 hours. Westminster residents receive 20% off. Sexually transmitted infections often show no early

How Soon After Sex Should You Test for STDs? Timing, Accuracy & What Londoners Should Know
Marylebone Diagnostic CentreResults within 24 - 42 hours. Westminster residents receive 20% off. After unprotected sex or a

How to Check Your Liver Health After Binge Drinking – Tests, Symptoms and Recovery Explained
Reviewed by Dr Lauren Holland • Marylebone Diagnostic CentreResults within 24 - 42 hours. Westminster residents receive 20%

Burning After Sex but No Discharge – Causes, Symptoms and When to Test in London
Reviewed by Dr Lauren Holland • Marylebone Diagnostic CentreResults within 24 - 42 hours. Westminster residents receive 20%

STD Testing After Unprotected Sex in London – What You Need to Know
Reviewed by Dr Lauren Holland • Marylebone Diagnostic CentreResults within 24 - 42 hours. Westminster residents receive 20%

Getting Your Health Checked Ahead of the Winter Season in London – Vitamin D, Thyroid, Mineral and Immunity Testing Explained
Reviewed by Dr Lauren Holland • Marylebone Diagnostic CentreResults within 24 - 42 hours. Westminster residents receive 20%

When a Home Test Isn’t Enough – Why a Private Diagnostic Blood Test in London Adds Real Value
Reviewed by Dr Lauren Holland • Marylebone Diagnostic CentreResults within 24 to 42 hours. Westminster residents receive 20%

Understanding Cholesterol, Lipid Markers, Vitamin and Mineral Deficiencies: What Every Londoner Should Know
Reviewed by Dr Lauren Holland • Marylebone Diagnostic CentreResults within 24 - 42 hours. Westminster residents receive 20%

What Famous Faces with Diabetes Can Teach Us About Early Testing
Reviewed by Dr Lauren Holland • Marylebone Diagnostic CentreResults within 24–42 hours. Westminster residents receive 20% off. When

Why Londoners Are Searching ‘Low Ferritin Symptoms’ More Than Ever
Marylebone Diagnostic CentreResults within 24 - 42 hours. Westminster residents receive 20% off. Over the past year, online

Blood Pressure Spikes in Young Adults: Why It’s Becoming More Common in London
Marylebone Diagnostic CentreResults within 24 - 42 hours. Westminster residents receive 20% off. High blood pressure is often

Dr Francesco Lo Monaco: One of London’s Leading Cardiologists
Why Many Patients Choose Him for Specialist Heart Care London has many cardiologists, but very few achieve the

Undiagnosed Thyroid Problems in Women Aged 30–55 in London
Reviewed by Dr Lauren Holland • Marylebone Diagnostic CentreResults within 24 - 42 hours. Westminster residents receive 20%

Hidden Symptoms of Low Testosterone in Men Over 35 in London
Reviewed by Dr Lauren Holland • Marylebone Diagnostic CentreResults within 24 - 42 hours. Westminster residents receive 20%

Silent Kidney Problems in People Who Think They Are Healthy
Reviewed by Dr Lauren Holland • Marylebone Diagnostic CentreResults within 24 - 42 hours. Westminster residents receive 20%

Hidden Diabetes in Young Adults in London: The Warning Signs You Should Not Ignore
Reviewed by Dr Lauren Holland • Marylebone Diagnostic CentreResults within 24 - 42 hours. Westminster residents receive 20%

Why Am I Waking Up Tired Every Day? The Blood Tests Londoners Should Consider
Reviewed by Dr Lauren Holland • Marylebone Diagnostic CentreResults in 24 - 42 hours. Westminster residents receive 20%

Hidden Vitamin Deficiencies in Busy London Professionals: The Symptoms You Should Not Ignore
Reviewed by Dr Lauren Holland • Marylebone Diagnostic CentreResults within 24 - 42 hours. Westminster residents receive 20%

How to Get a Blood Test in the UK
Reviewed by Dr Lauren Holland • Marylebone Diagnostic Centre, 73 Baker StreetPrivate blood tests in central London •

STI Testing in London – Your Complete Guide
Reviewed by Dr Lauren Holland • Marylebone Diagnostic Centre, 73 Baker StreetSame-day STI testing • Results in 24–42

Urine Changes Explained – When to Get Tested in London
Reviewed by Dr Lauren Holland • Marylebone Diagnostic Centre, 73 Baker StreetUrine analysis, urine culture, kidney screening •

Coagulation Profile Test – Cost, Results and How to Book in London
Marylebone Diagnostic CentreResults within 24 - 42 hours. Westminster residents receive 20% off. BOOK NOW A coagulation profile

NT-proBNP Blood Test – Price, Purpose and Fast Results in London
Marylebone Diagnostic CentreResults within 24 - 42 hours. Westminster residents receive 20% off BOOK NOW NT-proBNP is one

Squamous Cell Carcinoma Antigen (SCC) Test – Cost, Purpose and How It Works
Reviewed by Dr Lauren Holland • Marylebone Diagnostic CentreResults within 24–42 hours. Westminster residents receive 20% off -

Atypical Antibody Test – What It Checks & When You Need It
Reviewed by Dr Lauren Holland • Marylebone Diagnostic CentreResults within 24 - 42 hours. Westminster residents receive 20%

MRSA PCR Test – Same-Day Swab in London
Reviewed by Dr Lauren Holland • Marylebone Diagnostic CentreResults within 24 - 42 hours. Westminster residents receive 20%

Zinc IV Drip – Benefits, Safety, Price & When to Book in London
Reviewed by Dr Lauren Holland • Marylebone Diagnostic CentreResults within 24 - 42 hours. Westminster residents receive 20%

What Tests Should You Take After Sex? The Complete Guide for London Patients
Marylebone Diagnostic CentreResults within 24–42 hours. Westminster residents receive 20% off. Many people search online for clear guidance

Silent Heart Symptoms in Women Over 40: What Londoners Need to Know
Reviewed by Dr Lauren Holland • Marylebone Diagnostic Centre, LondonResults within 24 - 42 hours. Westminster residents receive

Early Stroke Warning Signs in Middle-Aged Men in London
Reviewed by Dr Lauren Holland • Marylebone Diagnostic CentreResults within 24 - 42 hours. Westminster residents receive 20%

Joseph Parker’s Positive Cocaine Test: What It Means and Why Drug Testing Matters More Than Ever
Reviewed by Dr Lauren Holland • Marylebone Diagnostic Centre Results within 24 - 42 hours. Confidential and discreet.

Why Am I So Tired? The Blood Tests You Actually Need
Reviewed by Dr Lauren Holland • Marylebone Diagnostic Centre, LondonFast results within 24 - 42 hours. Westminster residents

Vitamin D Deficiency in London: Symptoms, Testing and What You Should Do Next
Marylebone Diagnostic CentreResults within 24 - 42 hours. Westminster residents receive 20% off. Vitamin D deficiency has become

What Tests Should You Take After Unprotected Sex? Your Complete Guide (London)
Reviewed by Dr Lauren Holland • Marylebone Diagnostic Centre, 73 Baker StreetSame-day STI testing • Private & discreet

STD & STI Testing in London: Costs, Speed, Full Panels & Private Options Explained
Reviewed by Dr Lauren Holland • Marylebone Diagnostic Centre, 73 Baker StreetPrivate same-day STI testing • Results in

Antibiotic Resistance: What It Is, Why It Happens, and How Testing Helps in London
Reviewed by Dr Lauren Holland • Marylebone Diagnostic Centre, 73 Baker StreetFast private infection testing • Culture &

Urine Changes Explained: What White Particles, Bubbles, Leukocytes, and Protein Mean – and When to Get Tested in London
Reviewed by Dr Lauren Holland • Marylebone Diagnostic Centre, 73 Baker StreetUrine analysis, urine culture, kidney screening •

Do You Need an Urgent STI Appointment? What to Do After Exposure, Symptoms, or a Partner Testing Positive
Reviewed by Dr Lauren Holland • Marylebone Diagnostic Centre, 73 Baker StreetPrivate same-day STI testing • No waiting

How to Get a Blood Test in the UK: NHS vs Private Options in London
Reviewed by Dr Lauren Holland • Marylebone Diagnostic Centre, 73 Baker StreetPrivate blood tests in central London •

STI Testing in London – Your Complete Guide (Fast, Private & Accurate)
Reviewed by Dr Lauren Holland • Marylebone Diagnostic Centre, 73 Baker StreetSame-day STI testing • Results in 24–42

Well Woman Health Check in London: What Women Need at 40, 50 & 60
Reviewed by Dr Lauren Holland | Marylebone Diagnostic Centre, 73 Baker StreetPrivate women’s health testing • Results in

Why Does an Erection Go Away During Sex? Causes, Solutions, and When to Get Tested in London
Reviewed by Dr Lauren Holland – Marylebone Diagnostic Centre, LondonPrivate and discreet men’s health testing | Results in

Sperm Test London: What Men Are Really Searching For – Costs, NHS Delays, Private Options and What Your Results Mean
Reviewed by: Dr Lauren Holland - Marylebone Diagnostic Centre, LondonResults in 24–42 hours • Same-day appointments • QC-validated

Fast, Confidential, and Same-Day STI Tests in London
Sexually transmitted infections (STIs) are common and often silent - many people carry them without realising. The only

How to Detect Heart Problems Before Symptoms Appear
By Dr Lauren Holland | Marylebone Diagnostic Centre, London Heart disease remains the leading cause of death in

Understanding Semen Quality, Sperm Lifespan, and Fertility
Semen analysis remains one of the most informative tools in reproductive medicine. It provides insight into sperm production,

Hair Mineral Test UK – What It Reveals About Your Body
Your hair holds more than just style - it carries a record of your nutritional health. A hair

Testosterone Blood Test in London – When and Why You Should Check Your Levels
Testosterone is one of the most important hormones for men’s health. It affects energy, muscle mass, mood, fertility,

Private Blood Tests in London Without Referral – Fast Results at Marylebone Diagnostic Centre
Finding fast and reliable blood tests in London doesn’t need to be difficult. At Marylebone Diagnostic Centre (MDC),

Does Shockwave Therapy Work for Erectile Dysfunction?
Looking for a real solution to erectile dysfunction – without drama, pills, or embarrassment? Shockwave therapy at Androhaus

Análisis de Semen en Londres – Fertilidad Masculina con Resultados Rápidos
¿Qué es un análisis de semen? El análisis de semen (también conocido como prueba de fertilidad masculina o

فحص الحيوانات المنوية في لندن – أدق اختبار للخصوبة
ما هو فحص الحيوانات المنوية؟ فحص الحيوانات المنوية (Semen Analysis) هو اختبار معملي شامل يحدد قدرة الرجل على

Magnesium, Potassium & Modern Health: Why Londoners Are Suddenly Talking About Minerals – And Why Testing Matters
Reviewed by Dr Lauren Holland, Clinical Lead - Marylebone Diagnostic Centre, LondonResults within 24–42 hours (blood) | Hair

Analiza nasienia w Londynie – Test płodności dla mężczyzn
Czym jest analiza nasienia? Analiza nasienia (znana też jako badanie nasienia lub sperm test) to badanie laboratoryjne, które

Male and Female Infertility Assessments & 60+ Gene Testing – Why They Matter
Author: Dr Lauren Holland Fertility is a deeply personal subject and understanding it early can make all the

تحليل السائل المنوي (Sperm Analysis) في لندن – دليل شامل
ما هو تحليل السائل المنوي؟ تحليل السائل المنوي، ويُعرف أيضًا باسم تحليل خصوبة الرجال، هو فحص مخبري يقيّم

Women’s and Men’s Health: Tests You Should Know About
Author: Dr Lauren Holland Men and women experience very different health challenges throughout life - but one thing

How Diagnostics Link with Lifestyle: What Your Blood Tests Reveal About Your Habits
Author: Dr Lauren Holland You might think of blood tests as medical necessities - something you do when

Why Diagnostics in Community Settings Are the Future: Faster, Easier, Better
Author: Dr Lauren Holland Healthcare is changing. Long waiting lists, hospital backlogs, and limited GP access have encouraged

Understanding Your Results: What Do the Numbers Mean?
Author: Dr Lauren Holland Getting your test results can sometimes feel confusing - pages of numbers, abbreviations, and

Which Screening Package Is Right for You?
Author: Dr Lauren Holland Preventive health screening isn’t just for when you feel unwell. It’s about understanding your

Unique Services at Marylebone Diagnostic Centre
Author: Dr Lauren Holland When choosing a private clinic, patients want more than just a blood test -

High Blood Pressure in London: Testing, Prevention & Why Blood Tests Matter
Reviewed by Dr Lauren Holland - Medical Doctor Specialist in metabolic health, gynaecology and clinical diagnostics. A calm

Why Choosing a Community-Based Diagnostic Centre Makes Sense
Author: Dr Lauren Holland Healthcare has changed dramatically over the last few years. More people now prefer convenient,

How to Choose a Diagnostic Centre: Questions You Should Ask
Author: Dr Lauren Holland When it comes to your health, choosing the right diagnostic centre matters. A simple

“‘Fat Jabs’ Are Not a Permanent Solution: Why Diagnostic Insight Matters – MDC’s Approach to Weight & Metabolic Health”
When Quick Fixes Let Us Down: The Reality Behind ‘Fat Jabs’ A recent Telegraph headline warned that “fat

Nearly Half of People with Diabetes Don’t Know They Have It – Why Early Testing Could Save Lives
A recent Healthwatch report revealed a startling truth: nearly half of people living with diabetes - both in

Does Having an Abortion Reduce Fertility?
Short answer: For most people, no. When abortion care is provided safely and any after-care is followed, future

Does Testosterone Increase Muscle Mass Without Exercise?
Expert in diagnostic medicine, hormone health, and preventative care. Reviewed by Dr Lauren Holland - Medical Doctor Does

Private HIV Testing in London – Fast, Secure and Discreet
Many people search for “HIV lab test near me” when they want fast answers and privacy.At Marylebone Diagnostic

Hair Mineral Analysis UK – What It Shows and When to Consider It
Marylebone Diagnostic Centre, London Introduction Minerals play a key role in your health. They support your hormones, immunity,

Analiza spermei în Londra – Test de fertilitate pentru bărbați
Ce este analiza spermei? Analiza spermei (numită și analiza materialului seminal sau sperm test) este un test de

Private Blood Tests Near Soho, London – Fast, Accurate and Convenient
By Tharb Faisl Finding a reliable blood test in central London can feel confusing. With so many options

Understanding Key Blood Parameters: Venous Blood, eGFR, MCV, WBC, and Platelet Count
By Dr Lauren Holland | Marylebone Diagnostic Centre, London Blood testing is one of the most fundamental tools

Magnesium Deficiency and Fatigue: The Overlooked Blood Test That Matters
By Dr Lauren Holland | Marylebone Diagnostic Centre, London Feeling tired, tense, or struggling with poor sleep? You

HFMD Outbreak: What Parents in the UK Should Know About Hand, Foot & Mouth Disease
By Dr Lauren Holland | Marylebone Diagnostic Centre, London Recent reports from Tennessee have highlighted an outbreak of

CQC & Sir Julian Hartley: How Marylebone Diagnostic Centre Upholds the Highest Medical Standards
By Dr Lauren Holland | Marylebone Diagnostic Centre, London The Care Quality Commission (CQC) plays a vital role

Always Pads: Skin Reactions, Hormonal Balance, and When to Test
By Dr Lauren Holland | Marylebone Diagnostic Centre, London Recent discussions online about Always pads and potential skin

Paula Hudgell: Resilience, Recovery, and the Importance of Regular Health Checks
By Dr Lauren Holland | Marylebone Diagnostic Centre, London The remarkable story of Paula Hudgell - who adopted

Michael McIntyre and Stress in Modern Life: What Your Blood Can Reveal About Burnout
By Dr Lauren Holland | Marylebone Diagnostic Centre, London Comedian Michael McIntyre has spoken openly about the highs

Mauritania & Global Health: Why Early Testing Saves Lives Worldwide
By Dr Lauren Holland | Marylebone Diagnostic Centre, London From London to Mauritania, one message remains constant -

Universal Health: Why Prevention Is the Future of Medicine
By Dr Lauren Holland | Marylebone Diagnostic Centre, London Imagine a world where healthcare is not about waiting

Margaret & Menopause: Understanding Hormonal Change and Testing Options
By Dr Lauren Holland | Marylebone Diagnostic Centre, London Across the UK, thousands of women - like Margaret,

Heart Health: How to Detect Problems Before Symptoms Appear
By Dr Lauren Holland | Marylebone Diagnostic Centre, London Heart disease remains the leading cause of death in

The Great British Bone Check: Why Vitamin D and Calcium Testing Matters
By Dr Lauren Holland | Marylebone Diagnostic Centre, London As winter approaches and sunlight fades, millions across the

Antidepressants and Your Body: What Blood Tests Reveal About Side Effects
By Dr Lauren Holland | Marylebone Diagnostic Centre, London Antidepressants are among the most widely prescribed medications in

Brain Aneurysm: The Silent Threat and the Blood Tests That Help Detect Risk
Dr Lauren Holland | Marylebone Diagnostic Centre, London A brain aneurysm is often called a silent danger -

Cholesterol Medication Recalled – What It Means for Your Heart Health
By Dr Lauren Holland | Marylebone Diagnostic Centre, London. Book Now Recent headlines about a cholesterol medication recall

When It’s Too Late: Why Early Cancer Screening Matters More Than Ever
A GB News presenter and former UKIP London Assembly member has revealed a tragic stage four cancer diagnosis,

Why the UK Needs Prostate Cancer Screening – Lessons from Recent BBC Coverage
A recent BBC News article (14 October 2025) shared the story of Grant Aldred, a 58-year-old man from

World Mental Health Day: Why Science, Screening, and Early Care Matter More Than Ever
As the world marked World Mental Health Day, Oxford Health NHS Foundation Trust highlighted how cutting-edge research is

Understanding Semen Quality, Sperm Lifespan, and Fertility
Semen analysis is one of the most informative assessments in reproductive medicine.It provides clear insight into sperm production,

Private STI Tests in London – Fast, Confidential, and Same-Day
Sexually transmitted infections (STIs) are common and often silent - many people carry them without realising. The only

Why Footballers Rely on Blood Tests – and Why You Should Too
Every time Newcastle face Arsenal or Milan meet Napoli, fans watch the drama unfold on the pitch. But

Visa Medicals and Travel Blood Tests – Fast and Reliable in London
Airports like Zakynthos, Heathrow, and Gatwick are gateways for millions of travellers each year. But before flying, many

Stress and Health: What Protests and World Events Do to Your Body
When headlines break - such as the recent Liverpool protest - stress levels rise across the country. Protests,

Reality TV Stress – What Big Brother Teaches Us About Health
The return of Big Brother has once again caught the nation’s attention. Millions are watching contestants live under

Global Anxiety and Your Health: Why World Events Affect the Body
Headlines about conflict - such as the recent reports of a Russia attack on Poland - create waves

NHS Delays and Prescription Warnings – Why More Patients Choose Private Blood Testing in London
The NHS is one of the UK’s most respected health systems, but recent headlines have left many patients

Male Tests in London – Fertility, Hormones, and Health Screening
Men’s health is an area too often overlooked, yet early testing can prevent serious problems and improve quality

Private STD Tests in London – Fast, Discreet and Reliable
Sexually transmitted diseases (STDs) are common and can affect anyone who is sexually active. Early testing is the

Private Sperm Tests in London – Count, Quality, and Fertility Checks
For couples trying to conceive, or men simply curious about their reproductive health, sperm tests are one of

Private Medical Diagnostics in London – Why Marylebone Diagnostic Centre Is Your Trusted Choice
When people search for Medical Diagnostic Clinic, Harley Street Health Centre, or even Hartley Health Centre, what they

مركز تحاليل طبية في لندن | مركز مارليبون للتشخيص الطبي – نتائج دقيقة وسريعة خلال 24–42 ساعة
فحوصات الدم في لندن | Blood Tests in London | مركز مارليبون للتشخيص الطبي فحوصات الدم في لندن:

Why In-Clinic Blood Tests Are More Accurate Than At-Home Kits
By Tharb Faisl In recent years, at-home blood test kits have become increasingly popular. They promise convenience and

Hair Mineral Analysis (HTMA) in London – A Complete Guide
By Tharb Faisl Looking for a reliable hair mineral test in London? At Marylebone Diagnostic Centre (73 Baker

Could NAD+ Be the Secret to A Healthier Heart?
New study reveals SIRT1 link to lower cholesterol & fewer heart attacks When most people think of cholesterol
التوازن بين العمل والحياة في لندن: كيف تحافظ على صحتك في بيئة عمل سريعة الإيقاع
التوازن بين العمل والحياة في لندن | Work–Life Balance in London | مركز مارليبون للتشخيص الطبي التوازن بين

Will a Private Diagnostic Centre Cost More? Is It Worth It?
Author: Dr Lauren Holland Many people assume private healthcare always means expensive care. But when it comes to

Top 5 Tests You May Be Missing (But Should Consider)
Many people feel healthy but could still be missing vital health insights. Regular diagnostic tests can reveal hidden

Home vs Clinic Sperm Count Tests – Which Is More Accurate?
When couples start exploring fertility, men often look for the easiest way to check their sperm count. Online

Low Sperm Count – Causes, Signs, and How to Improve It
Low sperm count is one of the most common male fertility issues. Yet, it’s also one of the

Semen Analysis – Purpose, Procedure, and Results
A semen analysis is one of the most important tests in male fertility. It gives a detailed view

Sperm Count Test in London – Understanding Male Fertility
Fertility affects couples emotionally, physically, and socially. Yet, one in six couples struggle to conceive, and in nearly

Hormonal Acne, Irregular Periods, and Hair Growth – Could It Be PCOS?
When Everyday Symptoms Point to Hormone Imbalance If you're struggling with adult acne, unpredictable periods, or excess hair

Same-Day Drug and Alcohol Testing in London
Immediate Testing When It Matters Whether for workplace compliance, legal needs, or personal reassurance, our same-day drug and

Asthma Testing & Diagnosis – What You Should Know
Educational resource by Marylebone Diagnostic Centre (MDC) Understanding Asthma & Why Diagnosis Matters Asthma is a respiratory condition

Supplements, Lifestyle & Diagnostics for Male Fertility: What You Should Know
Infertility affects about 15 % of couples trying to conceive, and in roughly half of those cases, a

Heart Health Checklist: 8 Practical Steps to a Stronger Heart
At Marylebone Diagnostic Centre - your trusted heart screening & diagnostic partner in London Why Heart Health Matters

What the Headlines Tell Us About Health – And Why It’s Time to Take Control
From pneumonia scares to changing diets - 8 stories and what your body is trying to tell you

AMH Blood Test in London (Ovarian Reserve Test)
Fast, discreet results at Marylebone Diagnostic Centre What Is an AMH Test? AMH (Anti-Müllerian Hormone) is released by

The Science Behind Advanced Sexual Health Testing in London
Comprehensive, Accurate and Confidential Screening at Marylebone Diagnostic Centre Sexual health is central to overall wellbeing, yet many

What Are the Inflammation Markers?
When your body fights infection, injury, or chronic illness, it produces signs of inflammation. These signs can be

Mucinex and Fertility – Does It Work?
Fertility and pregnancy When trying to conceive, couples often explore every possible option. One surprising topic that comes

Fertility tests in London
Fertility tests in London offer a gateway to understanding reproductive health. They are essential for those planning a

Understanding Sperm Analysis: A Comprehensive Guide
Marylebone Diagnostic Centre73 Baker Street For many couples, the journey to parenthood doesn't always go as smoothly as

Semen Analysis and Male Fertility: Everything You Need to Know
Male infertility affects around 1 in 7 couples in the UK, and semen analysis is one of the

Understanding the Importance of Vitamin Deficiency Testing
In today’s fast-paced world, maintaining optimal health can be challenging. One of the key aspects of staying healthy

5 Key Reasons to Consider a Testosterone Test for Your Health
Testosterone plays a vital role in male health, yet many men in the United Kingdom overlook the importance

STD Testing Near Me – Discreet & Fast Results in Central London
When it comes to sexual health, privacy and speed matter. At Marylebone Diagnostic Centre (MDC), we offer same-day

Finding the Best Private Clinic Nearby – Marylebone Diagnostic Centre, 73 Baker Street
When it comes to your health, choosing the right clinic makes all the difference. Many people today are

TSH Blood Test Explained – What It Shows and Why It Matters
Book a private TSH blood test in London with same-day results at Marylebone Diagnostic Centre, 73 Baker Street.

Fertility Testing in London – Your Complete Guide for Men and Women
Private fertility testing in London with same-day results at Marylebone Diagnostic Centre. Understand your reproductive health with discreet,

D-Dimer Test in London – Why It Matters and Why It’s Not Enough Alone
When patients experience symptoms like sudden leg pain, swelling, or shortness of breath, doctors often want to rule

Shockwave Therapy Explained – How It Helps Injuries and Chronic Pain
Shockwave therapy is a non-invasive treatment for pain and injuries. Learn how it works, the conditions it treats,

Fat Loss Injections – Do They Work and Why Safety Testing Matters
Thinking about fat loss injections like Mounjaro? Marylebone Diagnostic Centre, 73 Baker Street, provides essential blood testing, safety

Shockwave Therapy at Marylebone Diagnostic Centre – Advanced Healing for Pain, Injuries, and Male Health
Marylebone Diagnostic Centre, 73 Baker Street, now offers shockwave therapy for sports injuries, chronic pain, wound healing, and
How Do I Get Tested for MRSA?
Hospital infections are a concern for many people. One of the best-known is MRSA (Methicillin-resistant Staphylococcus aureus). If

Choosing the Best Private Blood Test Clinic in London
By Tharb Faisl London is home to countless clinics offering private blood tests, but not all provide the

NHS Omeprazole Warning – Should You Get a Blood Test?
Why the NHS Is Warning Patients The NHS recently issued a warning about omeprazole, a widely used drug

DAO Enzyme Test – What You Need to Know
MDC & Laboratory Unexplained rashes, headaches, digestive discomfort, or fatigue can be frustrating. For some people, these symptoms

AMH Test – What Your Levels Mean for Fertility
AMH Testing Fertility can feel like a mystery. One important tool to understand it better is the AMH

What Blood Tests Should I Have Every Year?
By Tharb Faisl Preventing illness is always better than treating it. One of the simplest ways to stay

What is FBC? A Complete Guide to Full Blood Count Testing
By Tharb Faisl Blood tests are one of the most common investigations in healthcare. Among them, the Full

Mounjaro and Kidney Health – What Tests Reveal
Mounjaro is one of the newest medications for type 2 diabetes and weight management. Many patients are interested

Urine Test for UTIs – How It Works
Urinary tract infections (UTIs) are among the most common bacterial infections, especially in women. They can be painful,

Liver Function Blood Test (LFT) – What to Expect
By Tharb Faisl Book a private liver function blood test in London at Marylebone Diagnostic Centre, 73 Baker

Where to Book a Blood Test Near Me in London – Same Day Results at MDC
By Tharb Faisl Looking for a private blood test near you in London? Marylebone Diagnostic Centre offers same-day

How Long After Sex Should I Get Tested?
When it comes to sexual health, timing is everything. Knowing when to get tested for sexually transmitted diseases

Private Blood Tests in Marylebone – Same Day appointments
If you need answers fast, waiting weeks for a blood test isn’t an option. At Marylebone Diagnostic Centre,

Female Cancer Screening in London – What Every Woman Should Know
Private Cancer Marker Blood Tests for Women in Central London When it comes to female health, early detection

Private Cancer Screening in Harley Street – Early Detection Saves Lives
Why Cancer Marker Testing Matters Cancer doesn’t always show symptoms early.That’s why routine blood screening can make all

Hair Loss and Blood Testing – What Can Your Results Reveal?
Losing Hair? It Might Be More Than Just Genetics If your hair is thinning, shedding more than usual,

Private Male Fertility Test in Central London – Same Day Sperm Analysis
Check Your Sperm Health Privately and Quickly in London Trying to conceive? Wondering about your fertility?A sperm analysis

Trying for a Baby? Book Your Male Fertility Check Today
Your First Step to Understanding Fertility Starts Here If you and your partner have been trying to conceive,

Semen Analysis in Central London – Discreet, Same Day Testing
Understand Your Fertility with Same Day Semen Analysis If you’re trying for a baby or simply curious about

Urine Test for Infections – Private Testing in Marylebone
Fast, Accurate UTI Testing in Central London Experiencing a burning sensation when you urinate? Increased urgency? Cloudy or

MRI Scan and Blood Test Package London – Full Health Screening at MDC Baker Street
By Tharb Faisl The Power of Combining MRI Scans and Blood Tests If you’re looking for a complete

PCOS, Endometriosis and Infertility
Two of the most common conditions linked to female infertility are PCOS (polycystic ovary syndrome) and endometriosis. Both

Ovarian Cancer Blood Test – CA 125 Explained
What Is the CA 125 Test? The CA 125 blood test measures a protein that can rise when

Brain Fog & Neuro Health Profile – Advanced Neuro Screening in London
By Tharb Faisl Struggling with fatigue, memory loss, or migraines? Get answers without GP referral. Brain fog is

Female Fertility & Pelvic Health Profile – Comprehensive Women’s Health Screening in London
By Tharb Faisl Private fertility and pelvic health checks without GP referral For many women, fertility concerns or

MSK Injury & Joint Health Scan in London – Clear Answers for Pain & Injury
By Tharb Faisl Get clarity on joint pain, sports injuries, and back pain without GP referral Living with

What Are the Main Causes of Infertility in Women and Men?
Infertility affects around 1 in 7 couples in the UK. If you are struggling to conceive, you are

How Many Days After Your Period Can You Get Pregnant? (Fertility vs Age Explained)
Understanding your fertility window is one of the most important steps in planning a pregnancy. At Marylebone Diagnostic

Prostate Health Scan & Blood Profile – Early Detection in London
By Tharb Faisl Take control of your health with advanced prostate screening in Harley Street When it comes

Trichomonas & Mycoplasma: The Overlooked STIs Rising in London
When most people think of STIs, conditions like chlamydia, gonorrhoea, and syphilis come to mind. But in 2025,

Are At-Home Fertility Kits Reliable? Here’s What Doctors Say
The rise of at-home fertility kits promises quick answers from the comfort of your living room. From finger-prick

PGT-A Explained: The New IVF Genetic Test Improving Success Rates
For couples considering IVF, every decision carries emotional and financial weight. One of the latest advancements is PGT-A

AI and Male Fertility: Can a Blood Test Replace Semen Analysis?
Artificial intelligence is transforming every part of healthcare - and fertility testing is no exception. A recent breakthrough

The Rise of STIs in London: What Tests Should You Get in 2025?
Sexually transmitted infections (STIs) are on the rise across the UK, with London seeing the sharpest increase. According

Can Fertility Be Genetic? Understanding Your Risks
When couples struggle to conceive, one common question is: “Could infertility run in my family?”The answer is yes

Fertility Without IVF – Natural Ways to Boost Your Chances
When faced with difficulties conceiving, many couples immediately think of IVF. But not every fertility journey needs to

Fertility and Perimenopause – Is It Too Late to Conceive?
Perimenopause marks the years before menopause when hormone levels begin to change. Many women worry it’s “too late”

Fertility After Miscarriage or Birth – What Happens Next?
Experiencing a miscarriage or difficulties conceiving after having a child can be deeply emotional. Many couples wonder whether

Infertility: Where to Start and Which Fertility Screening Tests to Choose
If you and your partner have been trying to conceive without success, you may be wondering where to

PCOS, Endometriosis and Infertility – What You Need to Know
Two of the most common conditions linked to female infertility are PCOS (polycystic ovary syndrome) and endometriosis. Both

What Are the Main Causes of Infertility in Women and Men?
Infertility affects around 1 in 7 couples in the UK. If you are struggling to conceive, you are

Fertility Check in London – How Do I Test My Fertility?
If you’re planning a pregnancy, struggling to conceive, or simply curious about your reproductive health, a fertility check

How Many Days After Your Period Can You Get Pregnant? (Fertility vs Age Explained)
Understanding your fertility window is one of the most important steps in planning a pregnancy. At Marylebone Diagnostic

How Can I Boost My Fertility to Get Pregnant? (Fertility MOT London Guide)
Struggling to conceive can feel overwhelming. The good news is that there are steps you can take to

Private STD Panel – Advanced Sexual Health Blood Test London
Your Health. Your Privacy. Your Peace of Mind. Worried about a recent encounter? Experiencing unusual symptoms?Or simply due

Private PCOS Blood Test in Paddington – Take Control of Your Hormones
By Tharb Faisl Understand Your Hormones, Understand Your Health Struggling with irregular periods, acne, or unexplained weight gain?

AMH Blood Test for Fertility – Should You Get One?
By Tharb Faisl What Is the AMH Test and Why Is It Important? If you're thinking about having

The Triangle of Death: Skin Infections and Why Blood Tests Matter
By Tharb Faisl "Our cancer screening can be part of a broader longevity health screening, which checks multiple organ

Lyme Disease, Dartmouth, and the Importance of Infectious Disease Screening
By Tharb Faisl "Our cancer screening can be part of a broader longevity health screening, which checks multiple organ

Jessie J, Fertility, and the Role of Blood Testing
By Tharb Faisl "Our cancer screening can be part of a broader longevity health screening, which checks multiple organ

Mounjaro, Retatrutide, and Type 2 Diabetes: Why Monitoring Matters
By Tharb Faisl "For a more complete health assessment, many patients choose our MRI scan and blood test packages,

Davina McCall’s Health Message: Why Regular Blood Tests Could Save Your Life
By Tharb Faisl "For a more complete health assessment, many patients choose our MRI scan and blood test packages,

MRI Scan and Blood Test Package London – Full Health Screening at MDC Baker Street
By Tharb Faisl The Power of Combining MRI Scans and Blood Tests If you’re looking for a complete

Analize medicale private la Londra – Marylebone Diagnostic Centre pentru comunitatea românească
Analize medicale private la Londra – În siguranță cu Marylebone Diagnostic Centre Comunitatea românească este una dintre cele

Sexual Health Clinic in Marylebone – Confidential & Discreet
By Tharb Faisl "For a more complete health assessment, many patients choose our MRI scan and blood test packages,

Central London Diagnostic Testing – Fast Results
By Tharb Faisl "For a more complete health assessment, many patients choose our MRI scan and blood test packages,

Bilan de santé privé à Londres – Marylebone Diagnostic Centre pour expatriés français
Bilan de santé privé à Londres pour expatriés français Vivre à Londres en tant qu’expatrié français peut être

Private Blood Test London – Same Day Appointments
By Tharb faisl "For a more complete health assessment, many patients choose our MRI scan and blood test packages,

Longevity Health Screening London – Full Body MRI & Blood Tests at MDC Baker Street
By Tharb Faisl Future-Proof Your Health Longevity health screening is all about prevention and early detection. At Marylebone

Private Prostate MRI London – Fast Appointments & PSA Tests at MDC Baker Street
By Tharb Faisl Proactive Prostate Health Checks Prostate problems are common in men over 45, but early detection

Fertility Scan and Blood Test London – Same-Day Appointments at MDC Baker Street
By Tharb Faisl Clarity When You Need It Most When you’re trying to conceive, waiting for tests can

Private Cancer Screening London – MRI & Tumour Marker Tests at MDC
By Tharb Faisl Early Detection Saves Lives Cancer screening isn’t just for those with symptoms - it’s for

Private Health Screening London – Fast, Comprehensive Checks at MDC Baker Street
By Tharb Faisl Your Health, Checked Without Delay In today’s busy world, many people put off health checks

Private MRI Scan London – Same-Day Appointments at MDC Baker Street
By Tharb Faisl Skip the Wait – Book Your Private MRI in London Today If you’ve been told

Health MOT with MRI London – Full Body Check at MDC Baker Street
By Tharb Faisl Your Complete Health Check in One Visit A standard health check is good - but

MRI Scan and Blood Test Package London – Full Health Screening at MDC Baker Street
By Tharb Faisl The Power of Combining MRI Scans and Blood Tests If you’re looking for a complete

Vitamin Deficiency Test in Marylebone – Check Your Levels Today
By Tharb Faisl What is a Vitamin Deficiency Test and Why It Matters Feeling tired all the time?

Mounjaro and Male Fertility in London – What Men Need to Know
What Is Mounjaro and Why Are Men Concerned About Fertility? Mounjaro (tirzepatide) is one of the most talked-about

Male Infertility: What Causes It & The Top 5 Tests to Get in London
Understand the Causes of Male Infertility Male infertility affects more couples than you might think. Up to 50%

How Hormones Affect Male Fertility in London – What You Need to Test?
What Hormones Impact Sperm Production and Fertility? When it comes to male infertility, many people only think about

Mucinex and Fertility – Can It Really Help Sperm Quality or Cervical Mucus?
The Surprising Fertility Trend Around Mucinex If you've Googled fertility tips recently, you’ve probably seen people talking about

Male Infertility Testing in London – What to Do If You’ve Been Trying for 6–12 Months
Understanding the Male Role in Infertility If you and your partner have been trying to conceive for 6–12

What is NAD⁺ (and why is everyone talking about it?)
By Tharb Faisl Nicotinamide Adenine Dinucleotide (NAD⁺) is a vital coenzyme present in every cell. It plays critical

How Often Should You Get a Blood Test?
Your Health Is Always Changing - So Should Your Testing. Blood testing isn’t just for when you feel

IV Drips in Marylebone: Why Medical Oversight Beats Spa Treatments
By Tharb Faisl IV Drips Are Booming in London - But Are They Safe Everywhere? Walk around Marylebone

تحليل الخصوبة للرجال في لندن – نتائج دقيقة وسريعة بدون أي إحراج
هل تبحث عن تحليل الخصوبة للرجال في لندن؟في مركز Marylebone Diagnostic Centre، نقدم خدمة تحليل السائل المنوي للرجال

أفضل مركز تحاليل خاصة في لندن – في قلب بيكر ستريت وماريليبون
هل تبحث عن مركز تحاليل طبية موثوق في لندن؟مركز Marylebone Diagnostic Centre يقدم لك خدمات تحليل شاملة وخاصة،

Why Book a Private Semen Analysis in London?
When it comes to understanding your fertility, a semen analysis is often the first - and most crucial

NAD+ IV Therapy – Ultimate Anti-Aging Product in London
By Tharb Faisl When most people in London think of an “anti-aging product,” they imagine expensive serums, collagen

IV Therapy for Stress & Burnout in London
Anti‑Stress IV Drip London Why Stress Isn’t Just “In Your Head”? If you live or work in London,

IV Therapy for Immunity & Anti-Aging in London
By Tharb Faisl It’s Not Just About Looking Younger - It’s About Cellular Health. When Londoners think about

IV Hydration Therapy London – Medical Drips on Baker Street
By Tharb Faisl Feeling Dehydrated? Your Cells Might Be Struggling More Than You Think. Most people think dehydration

Why NAD+ IV Therapy is in a Completely Different League
By Tharb Faisl First, The Honest Science: They’re Not Comparable. Lots of London clinics love pushing Myers’ Cocktails

IV Drips in Marylebone: Why Medical Oversight Beats Spa Treatments
By Tharb Faisl IV Drips Are Booming in London - But Are They Safe Everywhere? Walk around Marylebone

Could NAD+ Be the Secret to A Healthier Heart?
New study reveals SIRT1 link to lower cholesterol & fewer heart attacks. When most people think of cholesterol

Urine Tests in London – Kidney, Infection & Miscarriage Risks | MDC
By Tharb Faisl Many people think a urine test is just to rule out a simple urinary tract

Grief & Stress Blood Tests in London
By Tharb Faisl Why Grief Affects More Than Just Your Emotions? We often think of grief purely as

Why Iron, B12 & Thyroid Matter More Than You Think
By Tharb Faisl Why This is About You - Not Just Elite Athletes. When people hear about nutrient

Why Book Your Immune & Nutrient Profile in London?
By Tharb Faisl Why a Simple Meal Can Sometimes Turn Dangerous? Headlines about food recalls - like the

Urine Tests in London – Kidney, Miscarriage & Infection Screening
Most people think a urine test is only for basic infections or diabetes checks. But this simple, painless

Folate Deficiency London – Tired or Losing Hair?
By Tharb Faisl What is Folate & Why Is It So Critical? Folate (vitamin B9) is a water-soluble

NAD+ IV Therapy London – Boost Energy, Focus & Longevity
By Tharb Faisl Tired, foggy, ageing faster than you’d like? Your cells might be desperate for NAD+ —

Common Misconceptions About Fertility and Hormone Testing
Separating Fact from Fiction with Marylebone Diagnostic Centre. Misinformation about fertility can delay timely care and create unnecessary

Fertility Check in Central London at Marylebone Diagnostic Centre
Why AMH Matters for Women Planning Pregnancy? AMH (Anti-Müllerian Hormone) is a key indicator of your ovarian reserve—the

eGFR Test London: What It Reveals About Your Kidney Health
Tharb Faisl Kidney health is a silent foundation of your overall wellbeing. One of the most powerful yet

Hair Loss, Fatigue, Low Immunity? Mineral Testing Might Be the Missing Link
By Tharb Faisl Are you tired all the time, losing hair, or constantly getting sick? It might not

Why Sperm Analysis Matters More Than You Think
Male fertility plays a crucial role in conception, yet it's often overlooked in early fertility assessments. At Marylebone

The Essential Cancer Screening Blood Test
By Tharb Faisl Cancer doesn’t wait. At Marylebone Diagnostic Centre, we believe in staying ahead of disease through

Male Cancer Screening in London: Why PSA Testing Matter?
By Tharb Faisl Prostate cancer affects nearly 1 in 6 UK men during their lifetime. Early-stage disease often

Mineral Hair Analysis London — When to Test Your Hair
By Tharb Faisl Hair Mineral Analysis (HTMA) is a non-invasive test that assesses the mineral content of your

IV Drips for Energy, Immunity & Recovery in London
By Tharb Faisl Feeling constantly tired, rundown, or foggy-headed? You're not alone. Many people in Central London are

Tired and Low in Nutrients? Book IV Therapy in London
By Tharb Faisl Are You Running on Empty? Long hours. Stress. Travel. Hangovers. Chronic fatigue. Whatever the reason,

Why Book Your Sperm Analysis in London Today!
Trying for a baby but not getting answers? You’re not alone - and sperm quality might be part

Mineral Hair Analysis – When to Test Your Hair
By Tharb Faisl Have you been feeling tired, foggy, or just “off,” even though your blood tests say

Can Mounjaro Affect Your Liver? Can It Cause Liver Damage? The Tests That Tell You the Truth
By Tharb Faisl & Dr Lauren Holland Many patients search online asking, “Can Mounjaro cause liver damage?” The

Is Mounjaro Safe for Long-Term Use?
By Tharb Faisl Mounjaro (tirzepatide) has become one of the most talked-about injectable medications for managing blood sugar

Low Energy, No Answers? Book Fatigue Blood Test Today
By Tharb Faisl Do you wake up exhausted, drag yourself through the day, and feel like no one

Allergy Blood Tests in London – Accurate, & Trusted by Locals
By Tharb Faisl If you suffer from unexplained symptoms like sneezing, fatigue, digestive issues, or skin rashes, allergies

Same Day Blood Tests London – Fast, Private, and Reliable
By Tharb Faisl When time matters, a same-day blood test can be the difference between peace of mind

Complete General Health Check Packages in London – What to Expect
Why Book a General Health Check? Your body doesn’t always shout when something is wrong — that’s why

Private Allergy Blood Testing in Central London – Get Answers Fast
By Tharb Faisl Why Allergy Testing Matters? Whether it’s hay fever, food reactions, or mystery rashes — allergies

Cancer Marker Blood Tests in London – What They Reveal & When to Test
By Tharb Faisl Why Consider Cancer Marker Testing? Cancer can develop silently, showing no symptoms until advanced stages.

Well Man vs Well Woman Blood Tests – What’s the Difference?
By Tharb Faisl Why Gender-Specific Health Screening Matters? Men and women experience different health risks at different life

Always Tired? What a Fatigue Blood Test Can Reveal
By Tharb Faisl Why Am I Always Tired? Constant fatigue can be frustrating and isolating. You may feel

General Health Check in London – The Power of Preventative Screening
By Tharb Faisl Why General Health Checks Matter? Too often, we wait for symptoms to appear before taking

Comprehensive Sexual Health Screening in London
Why Sexual Health Screening Matters? Your sexual health is a vital part of your overall wellbeing. At Marylebone

Inflammatory Markers – What CRP and ESR Reveal About Your Health
By Tharb Faisl What Are Inflammatory Markers? Inflammation is your body’s natural response to injury, infection, or chronic

Private Vitamin D Test in London – Are You Deficient Without Knowing It?
By Tharb Faisl The Silent Epidemic – Why Vitamin D Deficiency Is So Common, Vitamin D plays a

Female Hormone Test – Get Checked for Hormonal Imbalance in Central London
What Is a Female Hormone Test? A female hormone blood test checks the levels of key hormones involved

Private Diabetes Test in London – Check Your Blood Sugar & HbA1c Fast
By Tharb Faisl Could You Have Diabetes and Not Know It? Diabetes is one of the most common

Thyroid Function Tests – Is Your Thyroid Slowing You Down?
By Tharb Faisl What Is the Thyroid and Why Does It Matter? The thyroid is a small butterfly-shaped

Metabolic Blood Tests – What They Reveal About Your Organs
By Tharb Faisl What Are Metabolic Blood Tests? Metabolic panels are essential blood tests used to evaluate the

Lipid Profile (Cholesterol Test) – What Your Heart Wants You to Know
By Tharb Faisl What Is a Lipid Profile? A lipid profile, also called a cholesterol test, is a

Full Blood Count (FBC) – What It Reveals About Your Health
By Tharb Faisl What Is a Full Blood Count (FBC)? A Full Blood Count (FBC) is one of

Precision Health Check for Busy Professionals – What to Prioritise When You’re Short on Time
By Tharb Faisl Your Health Can’t Wait - Even If Your Schedule Says Otherwise. As a busy executive,

The Truth About Fatigue – Blood Tests That Can Help You Find the Cause
By Tharb Faisl Always Tired? It’s Not “Just Life”. Fatigue is one of the most common complaints among

Understanding Inflammation – What Your Blood Can Reveal About Long-Term Health
By Tharb Faisl Inflammation: Your Body’s Alarm System. Inflammation is the body’s natural response to injury or infection

Hair Loss in Men – Could a Blood Test Reveal the Cause?
By Tharb Faisl Losing Hair? It Might Not Be Just “Ageing”. While male pattern baldness is common, not

The Importance of Early Cancer Screening – Especially for Men Over 40
By Tharb Faisl Early Detection Saves Lives - But Many Men Delay Testing. Men are statistically less likely

Female Hormone Imbalances – What Testing Can Reveal
Hormones Aren’t Just About Periods - They Affect Everything. Women’s hormones are incredibly dynamic - and even slight

Should You Test Your Thyroid? Symptoms You Shouldn’t Ignore
By Tharb Faisl Your Thyroid Controls More Than You Think. The thyroid is a small butterfly-shaped gland in

What Does a Full Blood Count Tell You? The Test Every Adult Should Consider
By Tharb Faisl Your Blood Holds Clues to Your Health - Are You Listening? Whether you're feeling run

Why Vitamin D Deficiency Is More Common Than You Think
The “Sunshine Vitamin” You Probably Aren’t Getting Enough Of. Vitamin D is essential for strong bones, mental wellbeing,

Advanced Sexual Health Testing in London
Sexual Health Is Self-Respect, Not Shame. There’s nothing embarrassing about getting tested — in fact, it’s one of

IV Therapy in Central London – Is It Worth It?
By Tharb Faisl What Is IV Therapy? IV therapy — or intravenous therapy — delivers essential fluids, vitamins,

What Does the Cardiac Profile Test Include?
Heart Disease Is the Silent Killer - But You Don’t Have to Wait for Symptoms. Every 3 minutes,

Well Woman vs Health Screening – What’s the Difference.
Choosing the Right Health Check Starts with the Right Knowledge. At Marylebone Diagnostic Centre, we offer two of

How Often Should You Get a Blood Test?
Your Health Is Always Changing - So Should Your Testing. Blood testing isn’t just for when you feel

Functional Medicine Testing in London – What Can It Reveal?
By Tharb Faisl You eat well, you try to rest, but something still doesn’t feel right.Your standard blood

What Is Personalised Blood Testing? How It Works & Why It Matters
By Tharb Faisl No two bodies are the same - so why should your blood tests be? Personalised

Vitamin Deficiency Testing in London – Do You Really Need It?
By Tharb Faisl Vitamin deficiencies are incredibly common - yet they’re often misdiagnosed or overlooked.If you feel constantly

Well Woman Profile in London – What’s Included & Why It Matters
Women’s health is complex, powerful, and ever-changing. Whether you’re experiencing symptoms or simply want peace of mind, a

What’s Included in a Full Blood Test? Answers for Curious Patients
Many people hear the phrase “full blood test” but don’t really know what it checks. At Marylebone Diagnostic

Marylebone Health Screening Profile – Full Body Test in London
Your health is your most valuable asset. Whether you're feeling run down, planning a life change, or just

Advanced Sexual Health – STI Testing Near Baker Street
Your Sexual Health Matters - And So Does Your Privacy When it comes to sexual health, peace of

Cardiac Profile 2 – Protect Your Heart with Early Detection
By Tharb Faisl Heart disease is still the leading cause of death in the UK - and many people

What Is PSA and Why Every Man Over 40 Should Know About It
PSA stands for Prostate-Specific Antigen — a protein made by the prostate gland, which can be measured through a simple

Why Male Health Testing Could Save Your Life – A Guide for Men in London
Men are statistically less likely to visit the doctor, get blood tests, or talk about their health -

What Happens After Hormone Testing? Results Guide
So, You’ve Had Your Hormone Test – Now What? Getting your hormone blood test is just the first

Hormone Blood Testing in Central London
Whether you’re feeling fatigued, dealing with irregular periods, or simply checking your fertility - hormone testing is a

Hormonal Imbalances in Women – Hormone Testing in London
Hormones affect nearly every function in the female body — from your sleep and mood to your weight,

Understanding the Female Hormone Cycle
Your hormones shift dramatically over the course of your monthly cycle, influencing everything from mood and energy to

What Are Hormones? Hormone Test in London
Hormones are chemical messengers that travel through your bloodstream, telling organs and tissues what to do. They control

AMH Test in London – Understand Your Ovarian Reserve
By Mr. Tharb Faisl Want to Know More About Your Fertility? Start with the AMH Test at Marylebone

Mineral Hair Analysis Test in London
By Mr. Tharb Faisl What Is Mineral Hair Analysis - And Why Should You Consider It? Your hair

Thyroid Testing in London – Symptoms, Diagnosis & Private Help
By Tharb Faisl Tired, Moody, or Gaining Weight? It Could Be Your Thyroid. The thyroid is a small

Blood in Urine Without Pain or Period – Why You Shouldn’t Ignore It
By Tharb Faisl Spotting Blood in Your Urine Without Pain? It Could Still Be Serious. Finding blood in

STD Testing Near King’s Cross – Same-Day, Discreet & Accurate
By Tharb Faisl Fast, Private STD Testing – Just Minutes from Kings Cross. If you live, work, or

PCOS Testing & Symptoms – A Private Clinic Guide in London
By Tharb Faisl Polycystic Ovary Syndrome (PCOS) affects 1 in 10 women - but many don’t even know

Can Vitamin B12 Deficiency Cause Anxiety & Fatigue?
By Mr Tharb Faisl If you’re feeling anxious, tired, forgetful or foggy - but your GP says everything

STD Testing for Men in London – What to Expect & How Fast It Is
Tharb Faisl Sexually transmitted infections (STIs) don’t always cause symptoms - but they can still affect your health,

Irregular Periods & Hormone Imbalance – When to Get Tested
By Tharb Faisl If your periods are unpredictable, prolonged, or missing altogether - it's not something to ignore.

Irregular Periods & Hormone Imbalance – When to Get Tested
Marylebone Diagnostic Centre – 73 Baker Street, London, W1U 6RD Period Irregularity Isn’t Just a Cycle Issue -

STD Symptoms Women Often Ignore – Book Your STD Test Today!
By Tharb Sexually transmitted infections (STIs) don’t always announce themselves with obvious symptoms - especially in women. In

Why Private Healthcare in London is the Smart Choice
By Mr Tharb Faisl & Dr Caplin Merijo The NHS is Under Pressure Like Never BeforeRecent BBC reports

Thinking About Mounjaro for Weight Loss? Mounjaro safety test London
By Tharb Faisl What You Need to Know Before Starting Mounjaro Mounjaro safety test London – it’s more

Early Health Testing in London – Billy Joel & Sir Chris Hoy
By Mr Tharb Faisl & Dr Caplin Merijo When music legend Billy Joel recently opened up about unexplained

It’s Not Just About Sperm – Male Fertility Test London
By Mr Tharb Faisl & Dr Caplin Merijo Rethinking Fertility: More Than Just a Numbers Game When most

Male Fertility Testing in London
By Mr Tharb Faisl What If Fertility Isn’t Just About Sperm Count? When discussing male fertility testing London,

Blood in Urine – Why You Shouldn’t Ignore It
Blood in urine (female, no pain) can be easy to dismiss—especially if you're not menstruating and feel completely

Mineral Hair Analysis in London
By Mr Tharb Faisl & Dr Caplin Merijo Hair is often seen as just cosmetic, but it’s actually

Why an Early Health Check Matters and Where to Book in London
By Tharb Faisl & Caplin Merijo Health doesn’t wait — and recent public stories from celebrities remind us

Private Blood Tests & STD Testing Near Baker Street & Paddington
By Tharb Faisl Private Blood Tests in Baker Street If you’re looking for fast, accurate, and discreet private

Complete STD & STI Testing in London: Fast, Discreet & Reliable
Tharb Faisl What Is an STI Check-Up? An STI check-up or STD test is a private screening that

IV Therapy London: What It Is, Why It Works, and Where to Get It
By Tharb Faisl What Is IV Therapy? IV therapy London clinics offer direct delivery of essential nutrients into

STD Testing London Near Me – Same-Day Appointments
If you’re searching “STD testing London near me,” you’re not alone. Every year, thousands of Londoners seek reliable,

HIV: What You Need to Know | Private Testing in London
By Mr. Tharb Faisl & Caplin Merijo When Freddie Mercury passed away in 1991, the world lost a

Urinary Tract Infections (UTI) Testing in London
By Mr Tharb Faisl If you're experiencing discomfort when you wee, or needing to go more often than

How Long in the Sun for Vitamin D? Vitamin D Test in London.
By Mr. Tharb Faisl You’ve probably heard that getting sunshine boosts your vitamin D – but how much

Advanced Sexual Health Test
When it comes to your sexual health, accuracy, speed, and confidentiality matter. Whether you’ve had a recent encounter,

Female Fertility Profile: Reproductive Health Check
Understanding your hormonal balance is the first step in managing your reproductive health. Whether you're trying to conceive,

Do You Know Your Blood Type? ABO Grouping & Rh Factor Test
Many people don’t — but knowing your blood group and Rh factor could be life-saving. It plays a

Your Full-Body Health Check with One Blood Test in London
Feeling unusually tired? Gaining weight for no clear reason? Concerned about your long-term health? With the Marylebone Comprehensive

Fatigue Blood Testing in London
We all feel tired after a long day. But if you're constantly battling exhaustion — even after a

Heart Palpitations Testing in London
By Dr Caplin Merijo & Mr Tharb Faisl When your heart starts to race, flutter, or skip beats,

Private Fertility Blood Tests for Men and Women in London
Thinking about starting a family — or just curious about your reproductive health?At Marylebone Diagnostic Centre, we provide

Private PCOS Blood Test in London Made Simple
By Dr. Sarah Hamza Polycystic Ovary Syndrome (PCOS) affects between 10–20% of women — yet it often remains

Comprehensive STD Testing Near Paddington
By Tharb Faisl & Caplin Merijo Your sexual health deserves the same level of attention, care, and privacy

Same-Day Blood Tests in London
By Tharb Faisl & Caplin Merijo When it comes to your health, peace of mind shouldn’t have to

Private Travel Blood Tests in London
By Mr Tharb Faisl & Dr Caplin Merijo Preparing for international travel comes with excitement—and important responsibilities. At

Full Body MOT in London
By Mr Tharb Faisl When was the last time you checked in on your health - properly?A Full

Female Hormone Testing in London
By Mr Tharb Faisl If you’re feeling distant, disconnected, or just “not yourself,” it might be more than

Private STD Testing in London
By Mr Tharb Faisl & Dr Caplin Merijo In today’s fast-paced world, taking charge of your sexual health

Vitamin B12 Test & IV Therapy in London
Author: Mr Tharb Faisl & Dr Caplin Merijo Constant Fatigue? It Might Be a Vitamin B12 Deficiency Do

Vitamin D Deficiency Test & IV Therapy in London
By Mr. Tharb Faisl & Dr. Caplin Merijo Do you constantly feel fatigued, struggle with low energy, or

Book Your Iron Deficiency Test and Restore Energy in London
By Mr. Tharb Faisl & Dr. Caplin Merijo Do you constantly feel tired, dizzy, or out of breath—even

Private Sperm Analysis in London
By Mr Tharb Faisl & Dr Caplin Merijo If you're planning a family or simply curious about your

Private Female Fertility Profile in London: Get Clarity
By Mr. Tharb Faisl & Dr. Caplin Merijo Whether you're planning a family, exploring IVF, or simply want

Private Male Hormone and Energy Blood Test
Author: Tharb Faisl If you wake up tired, feel unmotivated, struggle to build muscle, or notice your drive

Loss of Libido in Men: Private Libido Blood Test
No energy. No interest. And no idea why? If your sex drive has disappeared, you’re not alone —

Private Fertility Testing for Men in London: What to Expect
By Tharb Faisl Fertility isn’t just about sperm — your hormones matter too. If you and your partner

Low Testosterone in Men
By Tharb Faisl Low testosterone — often called Low T — is far more common than many men

Private Erectile Dysfunction Test in London – Fast & Discreet
Author: Tharb Faisl Losing confidence in the bedroom? It might not be in your head — your blood

Why Choose a Private Health Check in London
Author: Tharb Faisl Your Health Deserves More Than Waiting Lists and Uncertainty. In today’s world, health shouldn't be

Private STD Test in London – Symptoms You Shouldn’t Ignore
Author: Tharb Faisl It’s Your Health — And You Deserve Clear Answers Sexually transmitted infections (STIs or STDs)

Tired All the Time? These Blood Tests Can Help Find Out Why
Author: Tharb Faisl Are you constantly waking up tired, struggling to get through the day, or feeling mentally

Health and Fitness Blood Test in London – Start Smart
Author: Tharb Faisl Don’t Just Guess – Test Before You Train. Whether you're joining a gym, starting a

Private Vitamin B12 Test in London – For Fatigue & Low Energy
Author: Tharb Faisl Vitamin B12 Deficiency: The Silent Cause of Fatigue You Shouldn’t Ignore If you're constantly exhausted,

What Does a Full Blood Count (FBC) Actually Tell You?
Author: Tharb Faisl It’s One of the Most Common Blood Tests — But What Does It Actually Measure?

Private Fertility Test in London: What to Know in Your 20s–40s
Author: Tharb Faisl Thinking About Your Future? Let’s Talk Fertility. Fertility isn’t only about trying for a baby

STD Testing for Couples in London
By Tharb Faisl Confidential. Same Day. Done Together. Peace of mind, together. Whether you're newly dating, moving in,

Low Testosterone? Book a Private Male Hormone Test
Author: Tharb Faisl Low energy. Mood swings. Belly fat. Is this just ageing — or could low testosterone

Get a Private Immunity & Inflammation Blood Test in London
Author: Tharb Faisl Tired, Foggy or Getting Sick Often? Your Immune System Could Be Trying to Tell You

Private Liver Function Blood Test in London
Author: Tharb Faisl Your Liver Works Hard – But It Often Shows No Symptoms Until It’s Struggling Your

Book a Private Cholesterol Blood Test in London
Author: Tharb Faisl Heart disease is still the UK’s number one killer, but many of the early risk

Private Anaemia Blood Test in London
Author: Tharb Faisl Feeling drained, foggy, or breathless? You might be low on iron, vitamin B12, or folate

Your Hormones Affect More Than Just Your Period
Author: Tharb Faisl Hormonal imbalances can affect far more than just your period — they influence your skin,

Your Thyroid Could Be the Hidden Cause of Fatigue, Weight Gain or Mood Swings
Author: Tharb Faisl Your thyroid may be small — but its impact on your overall health is massive.

Fatigue. Low Mood. Aches. The Silent Signs of Vitamin D Deficiency.
Author: Tharb Faisl Do you feel constantly tired, achy, or under the weather — even when you’ve had

Confidential STD Testing in London
Author: Tharb Faisl Your Health. Your Privacy. Your Peace of Mind. Sexual health is personal — and getting

Essential Blood Tests You Can Book Privately in London
Author: Tharb Faisl Get the Answers You Need — Without the Wait. Fast, Trusted & Reliable Private Blood

Boosting Reproductive Health
A Comprehensive Guide to the Fertility Diet for Men and Women to enhance Reproductive Health Written by Tharb

Cholesterol Tests & Blood Work Explained
Author: Tharb Faisl Blood tests are powerful tools that can uncover early signs of disease, nutritional deficiencies, and

Blood Test and it’s Benefits
Blood Testing Blood testing is a routine medical procedure that can provide valuable information about a person’s health.

Most common Sexually Transmitted infections!
Types of Common Sexually Transmitted Infections include: Chlamydia, Gonorrhoea, Mycoplasma genitalium, Mycoplasma hominis, Treponema pallidum, Trichomonas vaginalis, Ureaplasma

All You Need To Know About Blood Test
What is a blood test ? Regular blood testing is one of the most important ways to keep
Posted on SiriTrustindex verifies that the original source of the review is Google. Service was immaculate, clean, tidy and staff were super friendly. 4 mins walk from Baker Street Station. Highly recommend this clinic for elderly and everyone else. They do female hormonal profile which is useful for pre-menopausal. I did this profile 2 months ago and once again today. The best clinic in London, not doubt.Posted on SimonaTrustindex verifies that the original source of the review is Google. I traveled to Marylebone Diagnostic Centre to try their NAD+ IV Drip/ IV Therapy and it was great. They were busy but what a nice team, clean clinic and a few mins walk from Baker Street Station. Is NAD+ worth it? Yes, it’s worth it for energy boost, cognitive function and anti-aging cell repair. I have done a lot of research into NAD+ and I found out it does support a female with menopause like myself. Don’t ask me how and why, it’s working for me well. I tried this multiple times however, Marylebone Diagnostic Centre offers the best quality NAD+ in London. This is my 3rd time in 40 days. I will be going for many more. Update: I have done NAD+ 8 times since my original review. The best thing ever.Posted on Anit UnadkatTrustindex verifies that the original source of the review is Google. I was given a very warm welcome and offered refreshments. There was no waiting time in terms of being seen by the Doctor. Kudos to the Doctor that took the blood test because it was completely painless and I say this because I have had multiple blood tests carried from various clinicians and Phlebotomists and they have been painful or shall I say heavy handed. Also, wanted to add the Doctor was very helpful and listened to what I was telling her in regards to symptoms etc. Overall experience was superb. I would highly recommend the Marylebourne Diagnostics center.Posted on Stefano ZuccaTrustindex verifies that the original source of the review is Google. Sebastian treated my scar tissue with shockwaves and immediately after one treatment the mobility of my wrist improved dramatically. The facilities are very clean and the whole staff is very friendly. Highly recommended!Posted on Ekaterina Kolchina / RomadinaTrustindex verifies that the original source of the review is Google. I’m using this lab for a while now and never had any issues. Everyone is super nice, the quality and speed of the results are good. But today I first met Omar and he is beyond expectations - the gentlest! I felt nothing! ❤️🔥Posted on NadiaTrustindex verifies that the original source of the review is Google. Truly excellent. I came in yesterday for a private blood test after trying (and failing) for weeks to get one done on the NHS. I found the booking process online very simple and easy, with many timeslots to choose from (I managed to book for the same day). The staff was extremely friendly and helpful with answering questions when I called ahead of time. The clinic was very modern and clean, and the collection process was a breeze - I barely felt the needle. The website stated a 1-3 working day turnaround time for results, but I received the report the very next day, so they surpassed my expectations. Brilliant service that is reasonably priced, so I would highly recommend.Posted on Mary BiliruizcTrustindex verifies that the original source of the review is Google. I booked a fertility hormone test, super helpful staff and clear results. Special thanks to Mr Tharb, such a gentleman. I will be coming back for the IV session, as promised. I came back again today (27th of Aug 25) for another test at Marylebone Diagnostic Centre, as expected, great service. Clinic is super clean, lovely light music, I felt good while at the clinic. MDC should branch out and offer hyperbaric, I would come every week. Update: I came in today (12th of September 2025) for a regular check up, lovely staff, super clean clinic, smells great, and music is relaxing. I got offered free coffee, a bottle of sparkling water and chocolate :) The service at this clinic is unmatched, I do regular check-ups every two/ three weeks.Posted on CatherineTrustindex verifies that the original source of the review is Google. Brilliant service had to adjust the placement of iv but they was straight onto it would come again if was done this way very quick and easy to bookPosted on Isaac TurnerTrustindex verifies that the original source of the review is Google. I booked a semen analysis test at Marylebone Diagnostic Centre in London as part of a fertility check. The process was private, professional, and very straightforward. I received my results quickly, which gave me peace of mind and clarity about the next steps. For anyone trying to understand their fertility, needing a sperm test, or looking for a reliable diagnostic clinic in London, I would highly recommend this centre.Verified by TrustindexTrustindex verified badge is the Universal Symbol of Trust. Only the greatest companies can get the verified badge who has a review score above 4.5, based on customer reviews over the past 12 months. Read more










